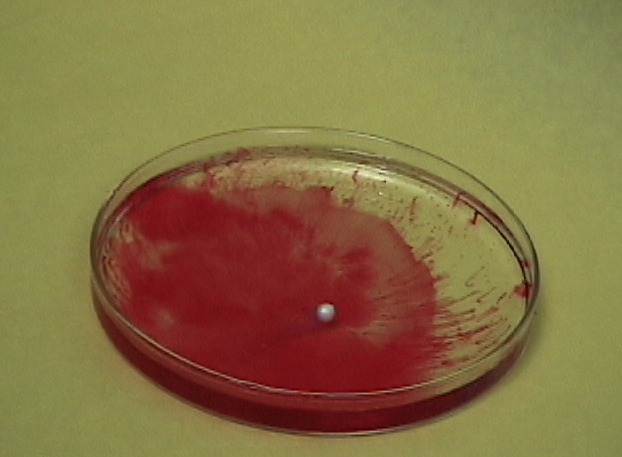

By Jen Lyman and Kami Heaton
Look above to see the iMovie we made!
Introduction
For our experiment, we are using sodium metal, phenolphthalein, and distilled water. Sodium is extremely reactive to water, and to be able to see the chemical reaction taking place, we use an indicator, phenolphthalein, to help us see the changes that occur. The materials we are using include: sodium metal, phenolphthalein, distilled water, goggles, apron,tweezers, scalpel, and a petri dish.
Safety Precautions
1. Wear an apron and goggles. Do not perform this experiment unless you are a chemist or have a supervisor.
Balanced Equations
Na(s) + 2H2O = H2(g) + 2NaOH
Procedures
First, you put the distilled water in the petri dish, and put in a few drops of the phenolphthalein indicator in the water. Second, use the tweezers to pull a peice of sodium from the container. Because sodium metal oxidizes quickly, cut off a small peice with the scalpel and put the rest back. And finally, drop the small peice of sodium into the water.
Any Questions?
What gas was given off?
Why does it change the color of the water?
Why does the sodium go into a sphere?
![]()
Sir Humphry Davy
Our chemisty experiment was founded by Sir Humphry Davy in the year 1807. Sir Humphry Davy was born on December 17, 1778, in Penzance, Cornwall, England. He received his education in Penzance and in Truro. His father died in 1794 and Davy became an apprentice to a surgeon-apothecary, J. Bingham Burlase, to help support his family. After reading Atoine Lavoisier's Traite Elementaire in 1794, Davy became interested in chemistry.
Many things happened the year Davy first tried this experiment, such as Robert Fulton inventing the first running steamboat. Also, the American Congress prohibited the importation of slaves, an act that was to take place on January 1, 1808, and the British retaliated against the Berlin Decree with an order in council (7 Jan) barring all shipping from the coastal track of France and her allies.